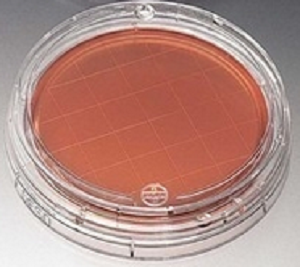
1%聚山梨醇酯80-玉米粉琼脂培养基

1%聚山梨醇酯80-玉米粉琼脂培养基
1% polysorbate 80-corn flour agar medium
询价
500g/瓶
起订
江苏 更新日期:2026-04-05
产品详情:
- 中文名称:
- 1%聚山梨醇酯80-玉米粉琼脂培养基
- 英文名称:
- 1% polysorbate 80-corn flour agar medium
- 产品类别:
- 培养基
公司简介
江苏菲亚生物科技有限公司是一家集研发、销售为一体的生物科技公司,公司秉承诚信、品质、服务的经营理念,对客户诚信负责,对工作精益求精,坚持高效、学习、务实、创新的企业精神,倡导忠诚、勤奋、创作、能力的人才理念,吸纳和培养了大批的高科技人才,建立了一支高素质的员工队伍。
公司以“致力生命科技,提升产品质量”为经营使命,为客户提供实验设计及相关试剂选配等技术服务,力求为客户提供*的服务。放眼未来,菲亚生物将继续专注于质控领域产品的开发,致力于成为领*的科研试剂供应商!
| 成立日期 | (11年) |
| 注册资本 | 1000万人民币 |
| 员工人数 | 1-10人 |
| 年营业额 | ¥ 100万-300万 |
| 经营模式 | 贸易,试剂 |
| 主营行业 | 化学试剂,生化试剂,细胞培养,诊断试剂 |
1%聚山梨醇酯80-玉米粉琼脂培养基相关厂家报价 更多
-

- 1%聚山梨醇酯80-玉米粉琼脂培养基
- 江苏雨桐生物科技有限公司
- 2026-04-05
- 询价
-

- 山梨醇;山梨糖醇
- 广州远达新材料有限公司 VIP
- 2026-04-11
- ¥30
-

- 吐温80 聚山梨酯-80 吐温 聚山梨酯
- 江苏奥福生物科技有限公司 VIP
- 2026-04-11
- ¥25
-

- 吐温80,聚山梨醇酯80,T-80,乳化剂,渗透剂,工业级,食品级
- 武汉普世达生物科技有限公司 VIP
- 2026-04-11
- ¥11500